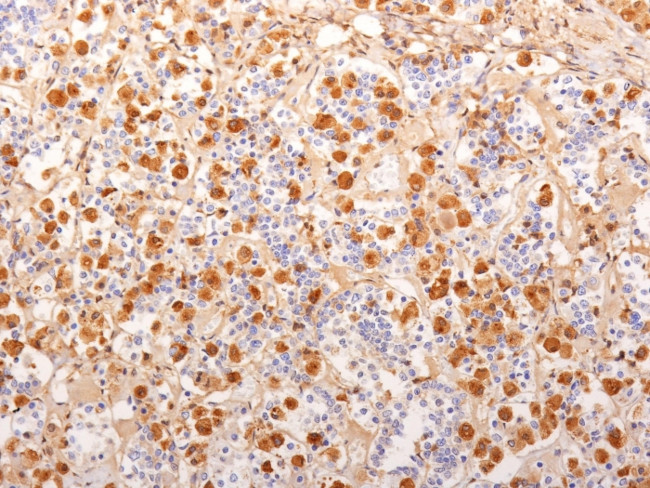
ACTH (Adrenocorticotrophic Hormone) (Pituitary Marker) Antibody in Immunohistochemistry (Paraffin) (IHC (P))

Search
NeoBiotechnologies
ACTH (Adrenocorticotrophic Hormone) (Pituitary Marker) Monoclonal Antibody (2F6)
{{$productOrderCtrl.translations['antibody.pdp.commerceCard.promotion.promotions']}}
{{$productOrderCtrl.translations['antibody.pdp.commerceCard.promotion.viewpromo']}}
{{$productOrderCtrl.translations['antibody.pdp.commerceCard.promotion.promocode']}}: {{promo.promoCode}} {{promo.promoTitle}} {{promo.promoDescription}}. {{$productOrderCtrl.translations['antibody.pdp.commerceCard.promotion.learnmore']}}
产品信息
5443-MSM4-P1ABX
种属反应
宿主/亚型
分类
类型
克隆号
抗原
偶联物
形式
浓度
规格
纯化类型
保存液
内含物
保存条件
运输条件
靶标信息
ATCH (adrenocorticotropic hormone) is a hormone which plays a major role in stimulating the adrenal cortex. It is formed through cleavage of the polypeptide precursor proopiomelanocortin (POMC), which also results in several other cleavage products including MSH, ACTH, and beta endorphin. ATCH is secreted from the anterior pituitary in response to the corticotropin-releasing hormone from the hypothalamus. It stimulates the secretion of glucocorticoids like cortisol, but has little control over the stimulation of mineralocorticoids like aldosterone, which is another major hormone of the adrenal cortex.
仅用于科研。不用于诊断过程。未经明确授权不得转售。
篇参考文献 (0)
生物信息学
蛋白别名: adrenal corticotropic hormone; adrenocorticotropic hormone; adrenocorticotropin; alpha-melanocyte stimulating hormone; alpha-melanocyte-stimulating hormone; alpha-MSH; beta-endorphin; beta-LPH; beta-melanocyte-stimulating hormone; beta-MSH; corticotropin-like intermediary peptide; Corticotropin-lipotropin; gamma-LPH; gamma-MSH; lipotropin beta; lipotropin gamma; melanotropin alpha; melanotropin beta; melanotropin gamma; met-enkephalin; opiomelanocortin prepropeptide; OTTHUMP00000119991; OTTHUMP00000200964; POMC; Precursor of MSH; pro-ACTH-endorphin; Pro-opiomelanocortin; pro-opiomelanocortin-alpha; proopiomelanocortin (adrenocorticotropin/ beta-lipotropin/ alpha-melanocyte stimulating hormone/ beta-melanocyte stimulating hormone/ beta-endorphin); proopiomelanocortin precursor; proopiomelanocortin preproprotein; proopiomelanocortin, beta (endorphin, beta); proopoimelanocortin, beta (endorphin, beta)
基因别名: ACTH; alpha-MSH; alphaMSH; BE; Beta-LPH; beta-MSH; CLIP; Gamma-LPH; gamma-MSH; LPH; MSH; NPP; OBAIRH; POC; POMC; Pomc-1; Pomc1; Pomc2
UniProt ID: (Human) P01189, (Mouse) P01193
Entrez Gene ID: (Human) 5443, (Mouse) 18976, (Rat) 24664